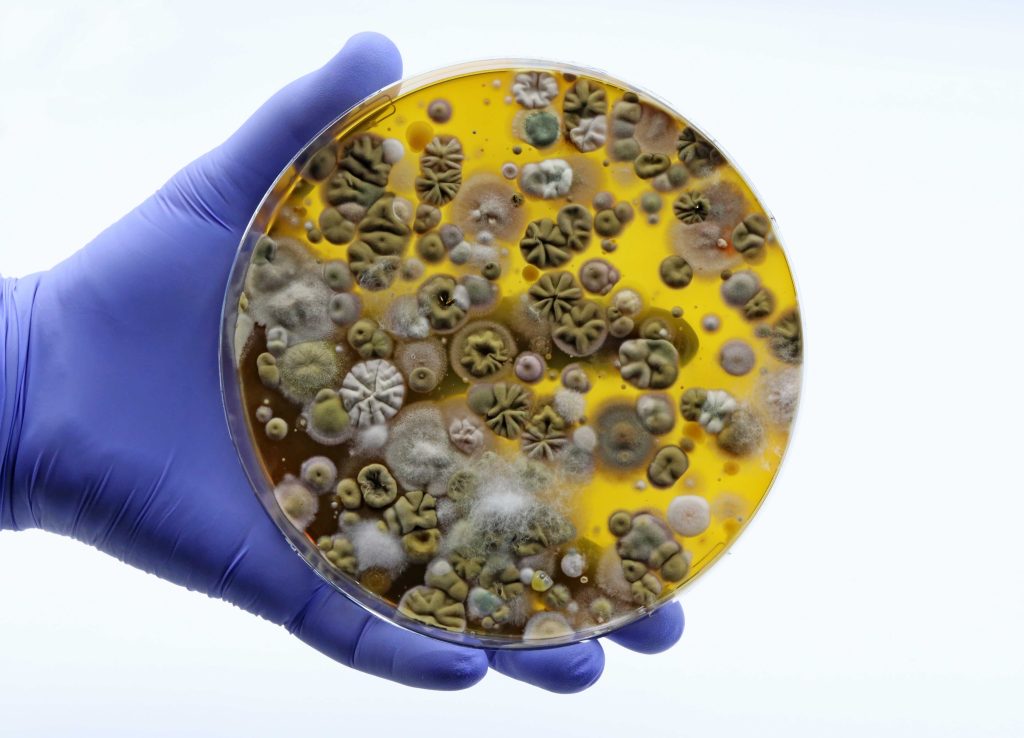
mold sampling, mould sampling in Ontario

Mould Sampling in Stratford, Ontario
Mould growth is a common concern for property owners in Stratford, Ontario, particularly in homes and buildings affected by moisture intrusion, flooding, high humidity, or aging construction materials. Because mould can impact indoor air quality, building materials, and occupant health, proper mould sampling and professional interpretation are essential when concerns arise. This article provides a […]
Mould Sampling in Stratford, Ontario Read More »